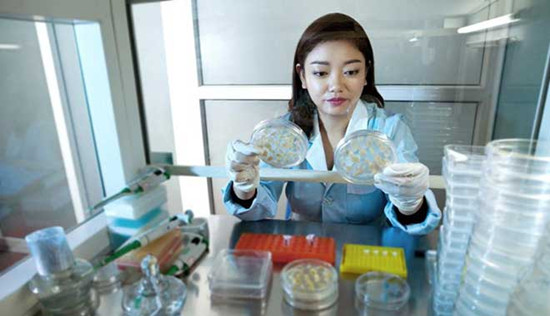
【中国梦实践者】“魔法师”卢艳丽:发掘抗逆基因 把玉米“点石成金” 【中国梦实践者】“魔法师”卢艳丽:发掘抗逆基因 把玉米“点石成金”

在很多人眼里,“种玉米”很难和“搞科研”划上等号。但是80后川妹子卢艳丽却用自己的坚持告诉我们:科研既可以非常“高大上”,也可以非常“接地气”。
作为四川农业大学玉米研究所所长,卢艳丽在玉米抗逆基因资源发掘与分子育种领域一干就是10多年,她发掘的这些抗逆基因有把玉米“点石成金”的魔力。
玉米是人类最为关键的农作物之一,它不仅是基本食物来源,从面包到软饮、从鞋油到牙膏,众多生活必需品的加工也都离不开玉米。近年来,利用玉米制取燃料乙醇,更成为了新能源开发的一大趋势。“如今人类迫切需要提高玉米的种植面积和单位产量,以满足全世界对食物、饲料、能源及工业原料不断增长的需求。”而这也正是卢艳丽的科研使命。
北方玉米“膀大腰圆”,能否“北玉南种”?很遗憾,正如“橘生淮南则为橘,生于淮北则为枳”,玉米品种的选育也必须因地制宜。四川所处的西南地区是我国玉米第三大产区,种植面积约占全国的15%,但是单产远低于全国平均水平。
为了让玉米适应阴雨寡照的气候和土壤贫瘠的山地,卢艳丽在玉米抗逆基因资源发掘与分子育种领域一干就是10多年,发掘了ZmARF31、ZmWRKY30等一批玉米抗逆新基因和SNP/InDel分子标记,培育了优良新自交系4个、突破性杂交玉米新品种10个,创造了显著的社会经济效益。
抗逆基因到底有什么点石成金的魔力?“有的基因能让玉米根系的侧根生长得更发达,有的是让玉米的主根吸收水分的能力增强,还有的则能让玉米遭遇干旱时提前开花……不同的基因具备不同的功能,我们要做的就是通过转基因技术把这些基因整合到玉米的基因组中,并通过分子标记筛选,确保这些基因能够发挥它的抗性作用,从而帮助玉米抵抗土壤干旱、营养贫瘠等逆境胁迫。”别看卢艳丽说得轻巧,科研的过程却是举步维艰。
玉米有多达10对染色体、约3.2万个基因、23亿个碱基,是人类已测序的基因数量最多的植物之一。海量的遗传数据带来了庞大而繁琐的工作量,但更令人崩溃的还有不可捉摸的环境和天气。“我们搞科研其实和农民耕种没什么两样,天天泡在田间地头,也得靠天吃饭。”卢艳丽对此颇感无奈,“遇到糟糕的天气,可能导致鉴定结果的不准确,遇到严酷的干旱,还可能颗粒无收。”
尽管科研过程并不容易,但卢艳丽心里丝毫没有退缩。“就像我们四川人打麻将,永不言败、推倒再来、血战到底!”她继承恩师荣廷昭院士的衣钵,成为了迄今为止玉米所最年轻的所长。
卢艳丽要像恩师一样,将自己的一生都奉献给科学和农业事业。(鸣谢:全国妇联宣传部)